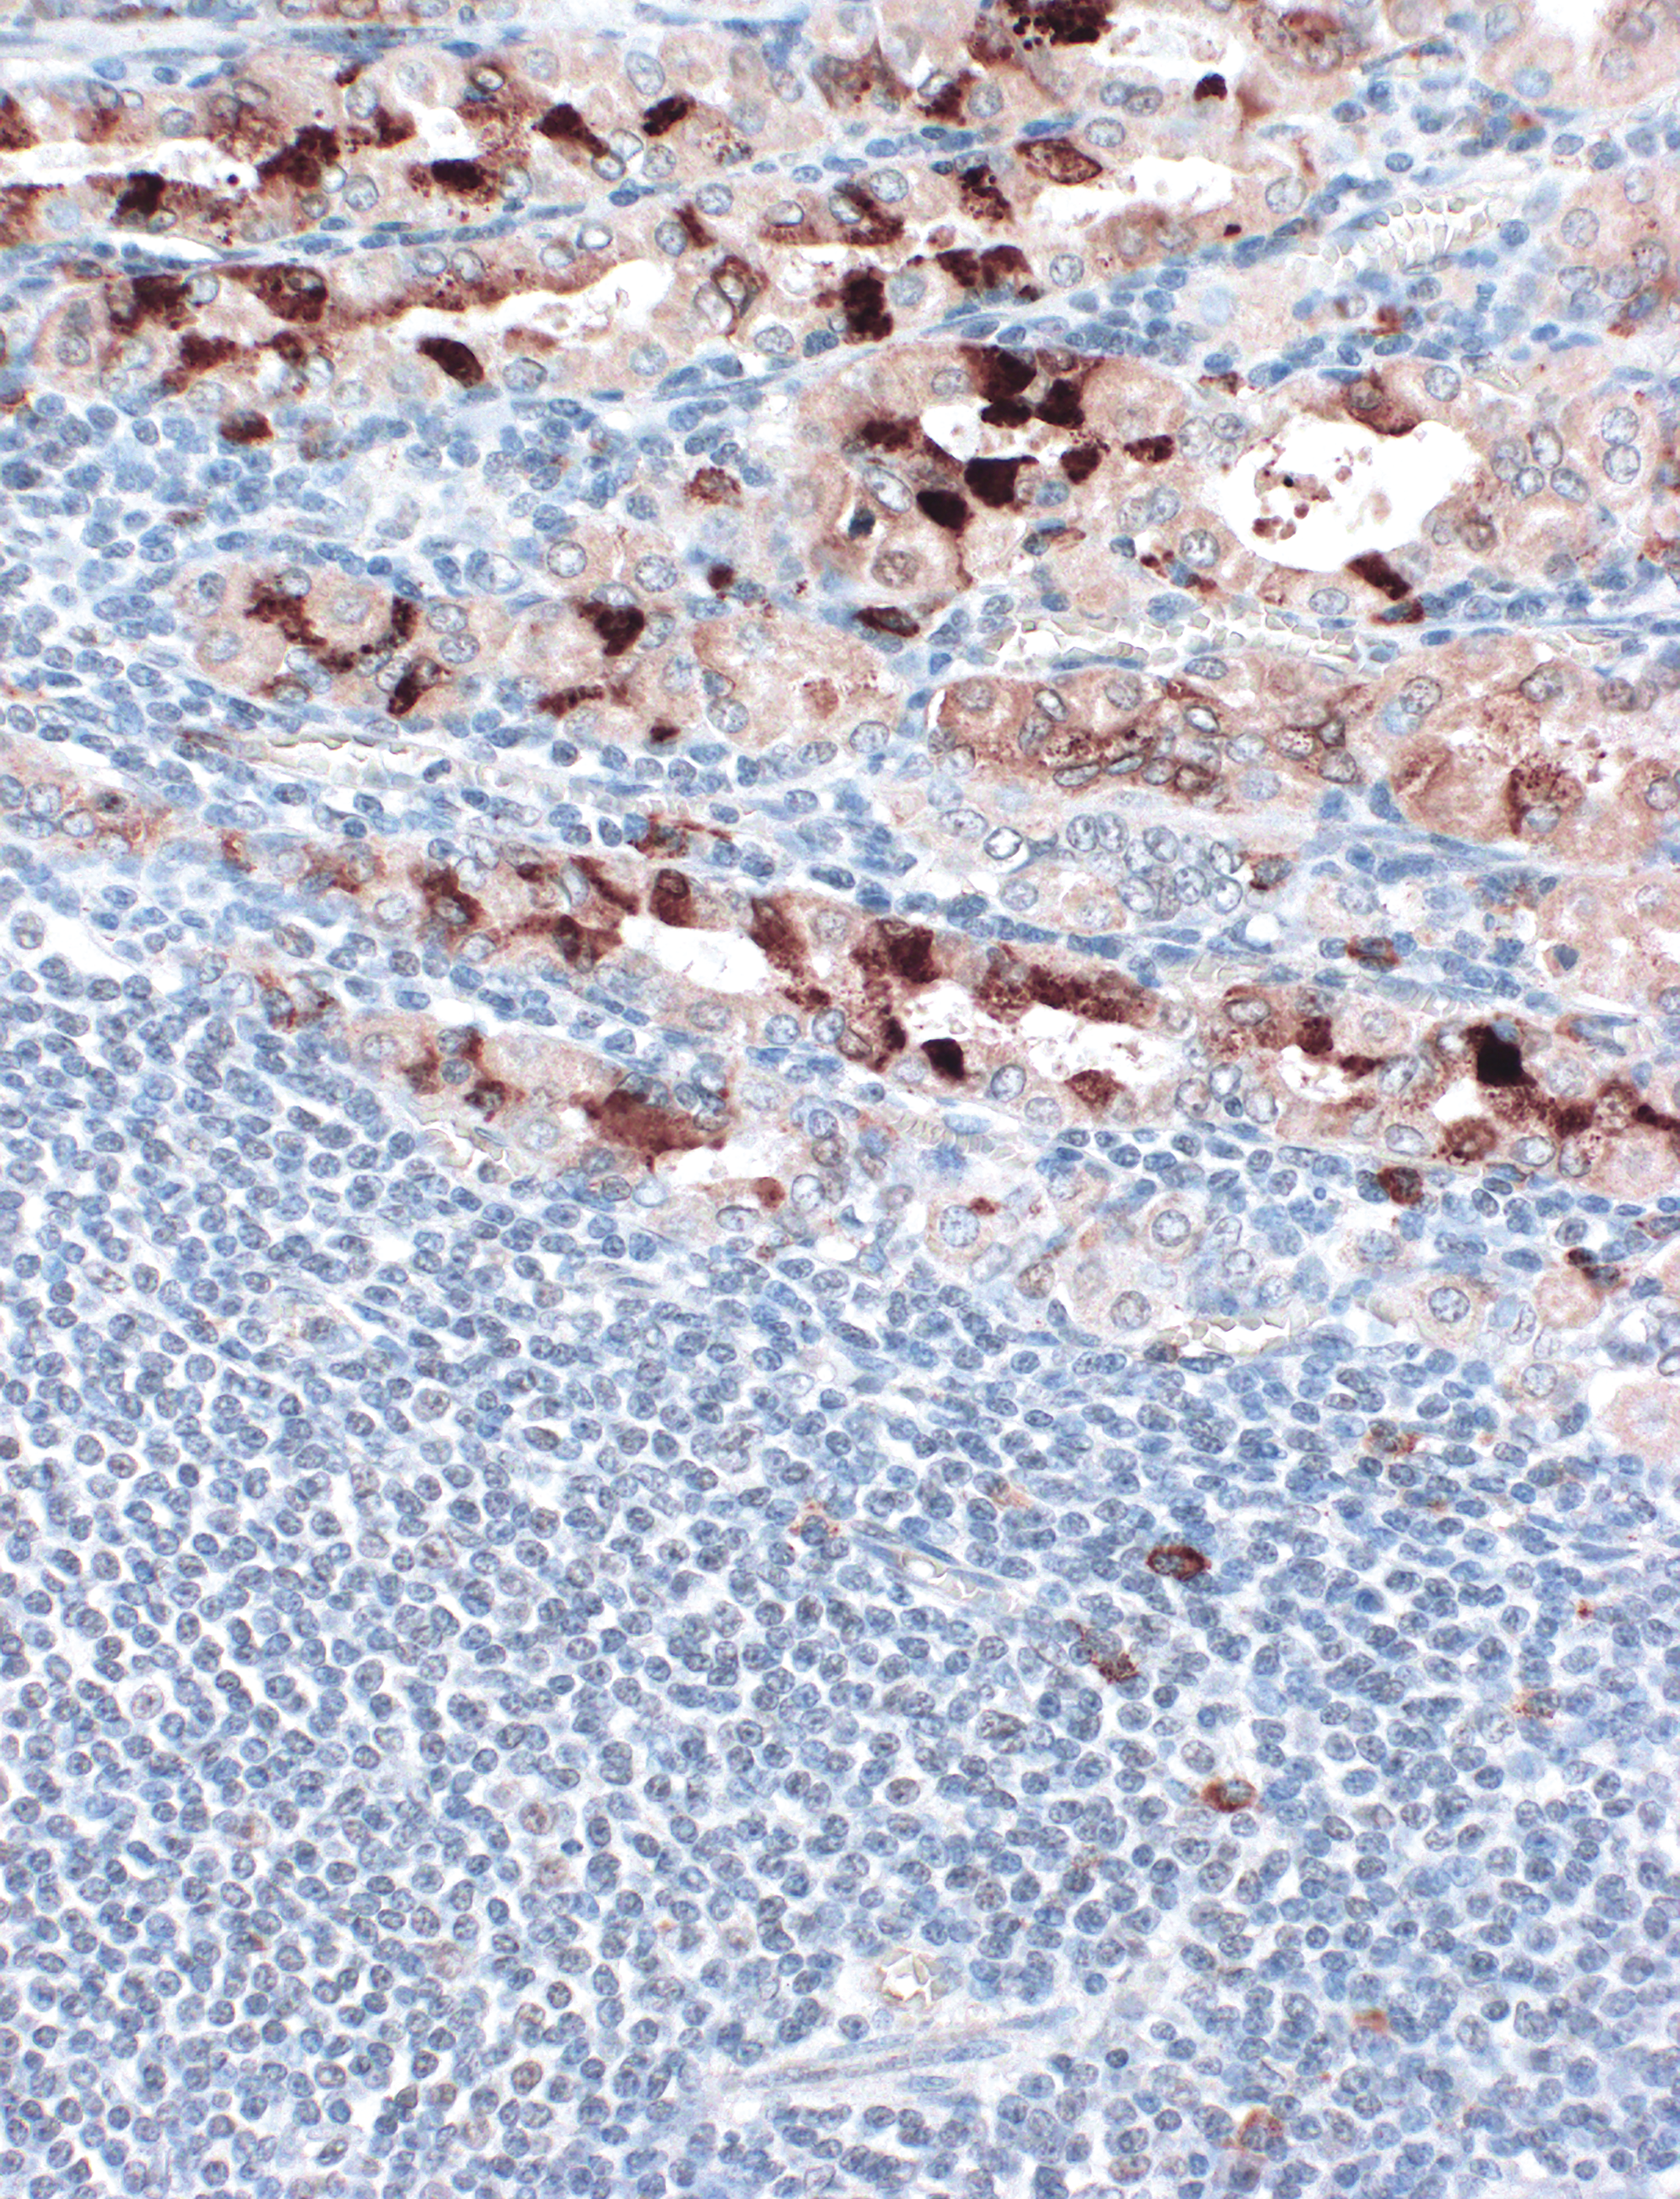
issue cover

Issue Archive
Table of Contents
BLOOD COMMENTARIES
REVIEW ARTICLE
EMZL at various sites: learning from each other
Extranodal marginal zone lymphoma (EMZL) of mucosa-associated lymphoid tissue is an indolent lymphoproliferative disease characterized by small heterogeneous B lymphocytes and is most often driven by chronic inflammatory reactions instigated by pathogens or autoimmunity. In this review, Du describes the complex pathophysiology of this disease, with a special emphasis on the distinct etiologies at different sites and how they trigger dysregulated immune responses that cooperate with genetic alterations and ultimately drive malignant transformation and clonal expansion.
HOW I TREAT
How I treat AML relapse after allogeneic HSCT
Relapse of acute myeloid leukemia (AML) after allogeneic hematopoietic stem cell transplantation (HSCT) is associated with a dismal prognosis and poses extraordinary clinical challenges. Gooptu and colleagues provide 3 case-based vignettes that outline their approaches to early and late relapse. The authors describe the role of detection of measurable residual disease and how evolving therapeutic options are incorporated in their proposed treatment algorithm.
CLINICAL TRIALS AND OBSERVATIONS
Measurable residual disease and posttransplantation gilteritinib maintenance for patients with FLT3-ITD–mutated AML
Clinical Trials & Observations
Recent studies suggest that the FLT3 inhibitor gilteritinib improves relapse-free survival in patients with detectable FLT3-ITD measurable residual disease (MRD) pre– or post–allogeneic hematopoietic cell transplantation for acute myeloid leukemia (AML). In this post hoc analysis of the MORPHO trial, Levis and colleagues provide new evidence, using a highly sensitive MRD assay, that quantitative FLT3-ITD MRD levels correlate tightly with clinical outcomes, therefore clearly identifying patients who are likely to benefit from gilteritinib maintenance therapy.
IMMUNOBIOLOGY AND IMMUNOTHERAPY
STING activation improves T-cell-engaging immunotherapy for acute myeloid leukemia
The bispecific T-cell engager AMG 330 is currently in clinical phase 1 trial for patients with relapsed/refractory acute myeloid leukemia (AML). In this preclinical study using cell lines and xenograft AML models, Linder and colleagues showed that cytotoxicity against AML mediated by AMG 330 was amplified when combined with a stimulator of interferon genes (STING). This effect was mediated by direct effects of STING activation on AML cells, and a feedback loop in which enhanced type I interferon production by the AML cells increased the cytotoxic T-cell phenotype.
LYMPHOID NEOPLASIA
CpG island methylator phenotype classification improves risk assessment in pediatric T-cell acute lymphoblastic leukemia
Unlike B-cell precursor acute lymphoblastic leukemia (ALL), T-cell ALL (T-ALL) lacks robust biomarkers for relapse risk prediction. Several T-ALL subgroups have been identified based on genomic alterations and transcriptomic profiles. In this study, Schäfer Hackenhaar and colleagues introduce the first epigenetic-based classifier for pediatric T-ALL. The authors describe 2 distinct epigenetic phenotypes, CpG island methylator phenotype high and low, and demonstrate the prognostic relevance of this classification, identifying both high- and low-risk groups of patients when measurable residual disease status at the end of induction was considered. Future studies that incorporate these findings with existing molecular markers are needed to provide a comprehensive molecular classification of T-ALL.
MYELOID NEOPLASIA
GATA2 links stemness to chemotherapy resistance in acute myeloid leukemia
The transcription factor GATA2 plays a critical role in the development and proliferation of hematopoietic stem cells. Alikarami and colleagues studied the contribution of GATA2 to chemotherapy resistance in acute myeloid leukemia (AML), proposing that GATA2 high expression levels in pediatric AML leukemic cells reflect the stem cell origin of these leukemias. In human AML cells and mouse models, the authors showed that AML originating from a mouse stem cell or immature progenitor cell population had higher Gata2 expression and was more resistant to chemotherapy. Mechanistically, they describe a role for GATA2 in modulating p53-mediated apoptosis via transcriptional regulation of RASSF4, a modulator of mouse double minute 2, determining a direct link between GATA2 levels and chemotherapy resistance.
The JAK2 46/1 haplotype influences PD-L1 expression
Brief Report
The JAK2 46/1 haplotype has been associated with an increased risk of developing JAK2-mutated myeloproliferative neoplasms (MPNs); however, the molecular mechanisms involved in this predisposition remain unknown. Carreño-Tarragona and colleagues describe a novel interaction between the JAK2 46/1 haplotype and PD-L1 expression. Using circular chromosome conformation capture which allows for the 3-dimensional organization of the genome, the authors identified a physical interaction between JAK2 and PD-L1 and a region within the JAK2 gene that transcriptionally regulates PD-L1 expression. Although the study does not provide a mechanistic role for PD-L1 in MPNs, it reveals a novel interaction that deserves further studies.
TRANSFUSION MEDICINE
Babesiosis and sickle red blood cells: loss of deformability, altered osmotic fragility, and hypervesiculation
Babesiosis is a tick-born disease caused by an intraerythrocytic parasite, which aggravates the hemolytic anemia of sickle cell disease and other hemoglobinopathies. In this study, Beri and colleagues describe the impact of Babesia divergens on human red blood cells (RBCs) with normal and abnormal hemoglobins. Using ektacytometry, the authors provide evidence for reduced deformability not only in sickle RBCs but also to a lesser degree in sickle trait and wild-type RBCs. They also report that infected sickle RBCs show increased osmotic fragility, loss of cell membrane, and increased release of extracellular vesicles. These findings set the stage for future studies on the mechanisms explaining how Babesia infection contributes to disease pathogenesis.
TRANSPLANTATION
Defining pathogenic IL-17 and CSF-1 gene expression signatures in chronic graft-versus-host disease
Chronic graft-versus-host disease (cGVHD) is the leading cause of nonrelapse mortality after allogeneic hematopoietic stem cell transplantation. The cytokines interleukin-17 (IL-17) and colony-stimulating factor 1 (CSF-1) have been implicated in the pathogenesis of cGVHD, and both are targets of current therapies, although responses remain variable. Boiko and colleagues used single-cell sequencing–based approaches in a mouse model of IL-17– and CSF-1–dependent cGVHD and identified nonintuitive RNA signatures of IL-17 and CSF-1 dysregulation in blood cells. The authors also found analogous signatures in monocyte subsets of patients prior to, and at, cGVHD onset. These findings may help identify patients who are likely to respond or not respond to relevant therapies.
BLOOD WORK
ERRATA
RETRACTION NOTICE
-
Cover Image
Cover Image
![issue cover]()
A microscopic image of gastric extranodal marginal zone lymphoma shows neoplastic B cells invading epithelial glands, causing them to undergo apoptosis and regeneration as well as reprogramming to produce human β defensin 2, which can inhibit
Helicobacter pylori colonization and activate B cells. See the review by Du on page 2117. - PDF Icon Front MatterFront Matter
- PDF Icon Table of ContentsTable of Contents
- PDF Icon Editorial BoardEditorial Board
Advertisement intended for health care professionals
Email alerts
Advertisement intended for health care professionals

From prognostication to precision in acute myeloid leukemia
Clinical Trials & Observations